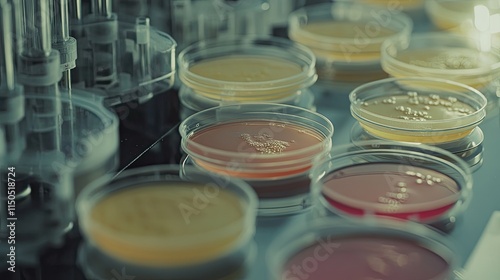

Multiple petri dishes containing diverse microbial colonies in a sterile lab environment for microbiological analysis.
Schlüsselwörter
biology,
horizontal,
laboratory,
medicine,
analysing,
microbiology,
one person,
photo,
research,
color image,
people,
biotechnology,
expertise,
growth,
disease,
science,
scientist,
working,
biochemistry,
check-up,
britain,
drugged,
plate,
adult,
equipment,
fungal,
adults only,
chemistry,
concentration,
confidence,
cut-out,
development,
diagram,
doctor,
examining,
graph,
man,
no people